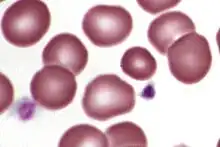

Microcyte
| Microcyte | |
|---|---|
![]() | |
| Microcyte. | |
| Specialty | Hematology |
A microcyte is an abnormally sized red blood cell. By definition it is 5 micrometers or smaller in diameter. It is often associated with several forms of anemia.[1]
References
- ↑ Meredith, Julie; Rosenthal, Nancy (August 1999). "Differential Diagnosis of Microcytic Anemias" (PDF). Laboratory Medicine. 30 (8).
External links
This article is issued from Wmcloud. The text is licensed under Creative Commons - Attribution - Sharealike. Additional terms may apply for the media files.